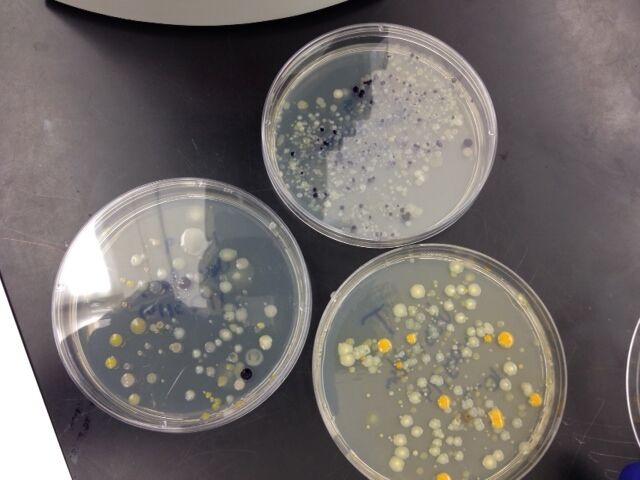

User:Adam Katzenberg/Notebook/Biology 210 at AU
Lab 6 02/31/2014 The purpose of this lab was to learn the stages of embryonic development, compare embryonic development in different organisms, and set up an experiment to study how environmental condictions affect embryonic development. In order to learn the stages of embryonic development as well as comparing embryonic development in different organisms, we will be looking at the different stages of development of a frog, starfish, and chick development at different stages. This will provide a good contrast between the development of different types of species. By doing so will provide us with insight into how more complex species such as humans have a more complicated system than the organisms due. Moreover, we will conduct an experiment using zebra fish embryos and observe their growth under different stresses. By doing this will provide insight onto how the environment affects development. The reason zebra fish will be affective at observing this is because they develop in two weeks and their shells are transparent allowing for embryonic observations to be made.
Procedure I: Starfish Development A series of starfish development images are displayed at a station, we are to observe the development of the starfish
Procedure II: Frog Development A series of frog development images are displayed at a station, we are to observe the development of the frog
Procedure III: Chick Development A series of chicken development images are displayed at a station, we are to observe the development of the chick
Zebra Fish Experiment Purpose: The purpose of this experiment was to test the effects of caffeine on the embryonic development of the zebra fish. Zebrafish eggs are good to use in experiments because the eggs are clear and develop outside of the mother's body. This allows the zebrafish egg growth to be witnessed easily under a microscope in comparison to other organisms. They also possess features that make them easy to maintain and observe in a lab. For example, their embryos develop rapidly, meaning experiments can be done at a reasonable speed. Zebrafish are vertebrates that possess relations to humans, meaning they are more likely to be similar to them in many biological traits like genes. For example, like humans, zebrafish possess a backbone, which means they are more closely related to humans than commonly used invertebrate models such as insects and worms. Therefore, the results of this lab can be utilized for the comparison of embryonic development of larger vertebrates such as humans, when affected by caffeine.
Hypothesis: We hypothesized that the treated caffeine group would have a smaller survival rate than the control group, as well as issues in developmental stages such as erratic movements and defects in size and eye proportion.
Prediction: If the treated zebrafish have received a significant dosage of caffeine, then they will display erratic movement, have wider eyes, and have a lower survival rate in comparison to the control group.
Procedure IV: Zebra Fish Experiment 40 healthy translucent eggs were gathered, 20 were for the control group and 20 were chosen for treatment group. 20 mLs of deerpark water was added to the petri dish containing the control group, and 20 mLs of 25mg caffeine /liter water was added to the treatment petri dish group. Then using a dropper 20 healthy translucent embryos were placed on each dish. The stages of the embryos was recorded. After the first 24 hours an observation was made on the development of the embryos and recorded. Then after the next 24 hours, the water was changed for both petri dishes, as well as observations recorded. Each recording contained, embryo height, developmental features, movement if hatched, and number that died. When the embryos were 4 days old, 10 mls of water with any egg cases was removed. 25 mls of fresh water was added. A week after the experiment began, 5 mls of water with any egg cases was removed and 5 mls of fresh water was added. 1-3 embryos from the control and experimental group were preserved in paraformaldehyde. Observations were made under the microscope each time the fish were treated.
Discussion The hypothesis and prediction were both well supported by the results. The caffeine treated zebrafish clearly displayed spastic, irregular movement in their mobility compared to the control group. The movements were especially abnormal because the final hatched fish had erratic body movements that differed from faster to slower pace. The space between the eyeballs in the zebrafish was also an apparent change. In the control group, the average length between the eyes was 6 micrometers.
-AK
Lab 5 02/24/2014 The Purpose of this lab was to understand the importance of invertebrates, as well as learn how simple systems (including specialized cells and overall body plan) evolved into more complex systems. First, this was accomplished by observing different types of worms at three different stations. The observations of the worms would provide detailed information about how the body plan affects the worm's movement, feeding, and overall survivability. Further more we observed the organisms that we extracted from our transect using the Berlese Funnel. Observing these organisms will provide us a contrast with the worms body plan. Moreover, after lab we will further research more complex organisms such as the Vertebrata and do further comparisons with the more simple organism body plans. Lastly, we conducted a food web of our transect in order to truly understand the ecological system happening at our transects.
Procedure I:Observing Acoelomates, Pseudocoelomates, and Coelomates Acoelomates, pseudocoelomates, and coelomates observation stations were pre-prepared for the comparison of invertebrates from the Berlese Funnel.
The three types of worms we observed in lab were the acoelomates Platyhelminthes or flat worms, the pseudocoleums, Nemotodas, and the coelmates, the earthworm. Because the flat worms are acoelomates they do not have a fluid filled cavity or coelem and are bilaterally shaped, I observed their movement to be stagnant. The Nemotodas are pseudocoleums, emaning they have an incompletely lined body cavity. I noted that their movement was a slow slither through the soil. However, the earthworm which is a coelmate, have a fully lined fluid-filled coelem. I observed their movement to be very mobile in soil as if they were gliding through the dirt.
Procedure II: Analyzing the Invertebrates Collected with the Berlese Funnel The Berlese Funnels were deconstructed and the preservative fluids were transported onto petri dishes. The invertebrates on the dishes were identified and observed using a dissecting microscope. Ten organisms were selected for measurement and observation.
Table of Organisms: 1. Ground Spider LL- Arachnids- 1 mm in length. The ground spider has no wings, no antennae, 2 body segments, and 8 legs. 2. Millipede- 4.5 mm in length. The millipede has no wings, 1 pair of antennae, several body segments, 2 pairs of legs on each side, and a round body. 3. Centipede- 5 mm in length. The centipede has no wings, 1 pair of antennae, several body segments, 1 pair of legs on each side, and a flat body.
- We were not able to see anymore organisms.
The range of the sizes of organisms that we collected in our Berlese funnel were from the 1 mm length spider to the 5 mm length centipede. The largest organism we found was the centipede. The smallest organism we found was the spider. The most common organisms in leaf litter are centipedes.
Procedure III: Vertebrates and Niches Vertebrates that are organized in the Biological Science textbook was used in order to identify five that might have inhabited the transect. The vertebrates phylum was described, and what abiotic and biotic characteristics might aid in it’s inhabitance of the transect. Based on the information a food web was created.
Five animals who might inhabit the transect:
1. American Robin- Chordata>Vertebrata>Reptilia>Aves>Turdus>Turdus Migartorius Biotic Characteristics that would benefit-Food such as insects and seeds Abiotic Characteristic that would benefit- Dirt for food to live in, man made feeders hanging from the trees for food
2. Song Sparrow- Chordata>Vertebrata>Reptilia>Aves>Melospiza>Melospiza Melodia Biotic Characteristics that would benefit-Food such as centipedes and arachnids and seeds Abiotic Characteristic that would benefit-Dirt for food to live in, man made feeders hanging from the trees for food
3. Voles- Chordata>Vertebrata>Mammalia>Eutheria>Aborimus>Aborimus Albipes Biotic Characteristics that would benefit- Plants and seeds for food. High bushes and trees for cover from predators. Abiotic Characteristic that would benefit-Dirt to house food
4. Wood Frog- Chordata>Vertebrata>Amphibia>Anura>Ranidae>Lithobates>Lithobates Sylvaticus Biotic Characteristics that would benefit- Food such as insects, high plants to keep hidden from predators, brown trees for camouflage Abiotic Characteristic that would benefit- Dirt to house food, park bench to hide under and for shade
5. Eastern Garter Snake- Chordata>Vertebrata>Reptilia>Lepidosauria>Colubridae>Thamnophis>Thamnophis Sirtalis Biotic Characteristics that would benefit- Noles and Wood frogs for food, plants to shade and hide from predators Abiotic Characteristic that would benefit- Dirt to attract smaller mammals for food, park bench to shade when hot and to stay hidden
Conclusion This lab provided insight into the major differences in body plans of organisms as well as contrast between invertebrates and vertebrate species. After designing the food web of my transect it was apparent that although there are many different types of organisms living the transect it is a cohabitation. Every species relies on the other one in order to survive no matter what body type or chordata it is apart of. The worms breakdown the soil for plants to grow to provide shelter for other organisms, which also allows bigger predators to survive to eat the smaller organisms.
-AK
Lab 4 02/21/2014
The purpose of this lab was to understand the characteristics and diversity of plants as well as appreciate the function and importance of fungi. This will be accomplished by obtaining plant samples from our transects and observing them. They will be observed under the microscope as well as characterized using a dichotomous key from a plant species book. Similarly, The fungi will be observed under a microscope at three stations of different types of fungi. Each fungi was learned about in class but it is important to be able to identify and see the fungi on a cellular level in order to fully understand the importance of them.
Procedure I: Collecting five plant samples from the transect Three bags were brought to transect for sample collection. The samples consisted of leaf litter, which was made up of soft soil and dead leaves. About 500grams of leaf litter was collected and placed into the bag. Then five samples of plant life were obtained to observe in lab.
Procedure II: Vascularization After the leaf samples were identified their vascularization were noted.
Procedure III: Plant Specialization The leaf samples were viewed under the microscope and their cells, shape, and characteristics were noted.
Procedure IV: Plant Reproduction After identifying the leaf samples, their reproduction process was identified by qualitative observations and then noted.
Procedure V: Observing Fungi If fungi were found on the agar plates, they were observed under a dissecting microscope. The fungi was then identified and drawn into a notebook.
Fungi Sporangia are small, black, globelike structures. Inside the sporangia are spores which are released when the sporangia open. They are important because it allows the fungus to spread to different environments. When the spores land on new environment more fungus is able to divide its cells and grow into more fungus. The most common fungus that uses this type of reproduction are the zygomycetes.
I think its a fungus because it contains spores and mycelium which are fungi characteristics. Also it was obtained from moldy bread, and mold is a known fungus.
Procedure VI: Setting up the Berlese Funnel to Collect Invertebrates In order to observe invertebrates from the transect, a Berlese Funnel was created a week in advance. The process included pouring about 25 mL of a 50:50 ethanol/water solution into a flask. A piece of screening material was obtained and fitted into the bottom of a funnel. The sides were taped so that the leaf litter did not fall into the preservative. The funnel was then placed into the neck of the square-sided bottle. The leave litter sample collected during procedure I was placed into the top of the funnel. Then a lighted 40-watt lamp was placed above the funnel with the incandescent bulb 1-2 inches from the top of the litter. Everything was then covered with foil and the light was left on for a week.
Conclusion This lab brought insight into the different plant species that are inhabiting my transect. Even though it is 20 ft by 20 ft there is a diversity that exists. This diversity can bring different species of animals that are attracted to that certain plant. It will be interesting to continue to observe the ecology occurring at the transect.
AK
Lab 3 02/21/2014
The purpose of this lab was to understand the characteristics of bacteria, observe antibiotic resistance, and understand how DNA sequences are used to identify species. In order to understand the characteristics of bacteria, we will be observing three different species of bacteria under a microscope and observing their characteristics. These characteristics include, shape such as bacillus, coccus, and spirilium, size, and whether or not they are gram-positive or gram negative, which provides insight into which have peptidoglycan in their cell walls.
Identifying and Studying Bacteria
Yes, I think archaea species will have grown on the agar plates. This is because of their extremophilic nature, meaning they can live in extreme environments such as hydrothermal vents near methane gas, and in environments with high concentrations of saline. Therefore, they should be able to grow on our lab agar plates.
Procedure I: Quantifying and Observing Microorganisms After a week of incubation, the agar plates were observed. The amount of colonies on each plate were counted and inputted into Table 3.
I noticed that the smell of our hay infusion culture decreased in potency. This could be due to the increased life that has grown inside of the jar eating the spoiled milk that initially made the hay infusion smell. Another reason could be that the smell from all of the hay infusion cultures overtook the smell of the room so it seems that there was no smell apparent.
Procedure II: Antibiotic Resistance The color of the colonies, the amount of the colonies, the shape of the colonies were observed from each plate and compared to the “tet” positive colonies on the agar plates.
Yes, there was a clear difference in the colony types between the plates with vs. without antibiotic. The plates with the antibiotic contained only white, yellow, and orange colonies, whereas the plate without the antibiotic had white, yellow, and purple colonies. This indicates that purple bacteria colonies are not antibiotic resistant, and white, orange, and yellow bacteria colonies are antibiotic resistance. Furthermore, orange colonies needed the antibiotic in order to grow. The effect of tetracycline on the total number of bacteria lowers the amount of colonies on the agar plates, this is because the bacteria have to be antibiotic resistant. For example, on the dilution plate 10^-3 with agar nutrient there was an uncountable amount of bacteria colonies growing, in comparison on the 10^-3 with agar nutrients and tetracycline, there were around 48 X 10^3 per ml. Although there were still a lot on the tetracycline plate it did not match the amount of on the non tetracycline plate. We did not have any fungi growing on our plates so I am not sure how the tetracycline affected fungi. I found that three species are unaffected by tetracycline, orange, white, and yellow. This is because they appeared on the agar plates with tetracycline.
Tetracycline inhibit enzyme reactions needed for bacterial cells. It works by binding to 30S ribosome of bacteria, and then stops the attachment of the aminoacyl tRNA to the RNA-ribosome complex. The types of bacteria that are sensitive to this antibiotic are E. coli, Haemophilus influenzae, Mycobacterium tuberculosis, and Pseudomonas aeruginosa.
Procedure III:Bacteria Cell Morphology Observations Out of the colonies obtained, three were chosen to have the DNA analyzed, wet mounted, and Gram Stained. Two were chosen from the regular plates and one was chosen from a “tet” positive plate. All three colonies were observed on a wet mount and the observations were noted. Afterwards a gram stain was made for each colony. This process began by first labeling slides. Then the colonies were heated and smeared onto the labeled slides. For each slide the same process occurred. The slide was covered with crystal violet for one minute, and then rinsed with water. Then the slide covered with Gram’s Iodine mordant for one minutes and rinsed gently with water. Next the slides were flooded 95% alcohol for 10-20 seconds in order to decolorize the slides. The colony was then stained with safranin for 20-30 seconds and rinsed. Finally, once the slide was dried it was observed under 40x magnification under a microscope. If the bacteria were gram positive a blue color would show, conversely, if the bacteria were gram negative a pink color would appear.
 According to the table it was clear that it was tough to truly separate the types of bacteria. They looked very similar under different magnifications, however the one stark contrast was the circular bacteria and the rod shaped bacteria.
According to the table it was clear that it was tough to truly separate the types of bacteria. They looked very similar under different magnifications, however the one stark contrast was the circular bacteria and the rod shaped bacteria.
Procedure IV: Start PCR Preparation for DNA Sequence Identification After the group characterized the three bacteria from their Hay Infusion Culture. One colony with the best characterization was chosen to be DNA sequenced using PCR reaction. The DNA was isolated using two primer sequences 27F and 519R in order to amplify the 16s rRNA gene. Process required obtaining a sterile tube and adding the colony in 100 uL of water. The tube was then incubated at 100°C for 10 minutes and centrifuged. The 5 uL of the supernatant in the PCR reaction was sent to a lab for DNA sequencing.
Conclusion After the DNA sequencing were returned it was apparent that the only identifiable bacteria were the 10-3 Yellow and were found to be Flectobacillus Lacus bacteria. Moreover, it is apparent that bacteria can thrive in any condition. This is because the amount that was able to grow in a few short days. Similarly, there were bacteria that were able to grow on antibiotic surfaces which was surprising. Evolution has selected those bacteria to survive against tools humans use to fight against disease.
-AK
Lab 2 02/09/2014 The purpose of this lab is to understand how to use a dichotomous key as well as understanding the characteristics of algae and protists. A dichotomous key is a tool used in order to identify any group of organisms. It works by observing key features of an organism and comparing it to verified data in order to figure out what group the organism belongs to. This will be done by observing Red algae, Brown Algae, and Euglenids and identifying each based on a dichotomous key. I hypothesize that the red and brown algae will be identified by its color and the euglenids will be identified by its flagellum.
Procedure I: How to use a dichotomous key First we made a wet mount of the sample with the known organisms and observed with the microscope at 4x and 10x. Then we characterized the organisms and described their size using the ocular micrometer. We then obtained a key with eight known organisms and used the key to determine the identity of the organism. We repeated these steps with a second organism as well.
Procedure II:Hay Infusion Culture A week after the Hay Infusion Cultures were prepared, they were observed, describing the smell and appearance. A few samples were gathered from two different niches within the jar for microscopic observation. The location from where the samples were taken was then noted. A dropper was used to place a small drop of liquid from the culture onto the microscope slides and a cover slip was placed on top. Three organisms from two different niches were observed. While observing the organisms under the microscope a picture was drawn of each, the size was observed, the mobility was noted, the organism type was identified, and whether each organism utilized photosynthesis as a food source was described. When we first created the Hay Infusion Cultures Jars the water was clear, the plants were alive, and the smell was clean. After a week, when the observed the jars there was a stark transformation. The water was murky and dirty, the smell of the jar had a strong spoiled milk smell. A thin sludge film covered the top of the water in the jar, and a thick sediment of sludge settled at the bottom of the jar. The plants were no longer vibrant greens, they turned brown and dead with the water.
The organisms near vs away from the plant will be different because on a microscopic scale they are two different habitats therefore the species inhabiting the area will be different. For example, the species closer to the plant might be using the plant as a food source, whereas the species away from the plant may eat the denser sediment on the bottom of the jar.
We obtained our samples from the top film layer and from the bottom sediment sludge of the hay infusion cultures.

3 Organisms from Bottom Niche- Gunk on Bottom 1. Pandorina- 250 micrometers, green algae, pandorina genus, mobile using flagella. 2. Paramecium Aurelia-140 micrometers, paramecium genus, mobile using cilia. 3. Paramecium Bursaria- 90 micrometers, protozoan, paramecium genus, mobile mobile.
3 Organisms from Top Niche-top film layer of water 1. Arcella- 60 micrometers, Arcella genus, mobile 2. Chlamydomonas- 12 micrometers, green algae, Chlamydomonas genus, mobile with flagella 3. Chilomonas - 32 micrometers, chryptophyte, protozoa, chilomonas genus, mobile with flagella
Paramecium Bursaria Freemen describes five things essential to life; energy, cells, information, replication, evolution. The paramecium bursaria meets all of the criteria. It is a protozoa, meaning it is motile and is unicellular. Within the cell there is a nucleus that contains its DNA or information. Because it is a paramecium it replicates asexually through binary fission. It consumes algae for energy therefore it is heterotrophic.
If the hay infusion culture had been observed for another two months I would predict that the water would be darker in color because of the constant replication of the organisms already there the water will become denser with algae and protozoans. The smell would be harsher because of the build up of algae. I would also predict that mold will start to develop on the top layer of the water, because it is a habitat conducive for mold; wet, warm, and plenty of food for it to consume.
Selected pressures that affected the composition of the culture would include size of the environment. Relative to the size of the organisms, if it is considered a big environment for smaller organisms there is more space for different habitats such as near the plants, top of the water, or bottom of the water, however if the organisms are bigger there is a higher competition for food sources and habitats therefore the fittest organisms would survive. Another selected pressure would be reproduction for the organisms. If there is not a lot of room for bigger organisms as they reproduce there is more competition for food and space therefore not many of them would survive at a given time.
Procedure III: Preparing and Plating Serial Dilutions In order to view the bacteria growing in the transect, a serial 100-fold dilutions were made from the cultures and then inoculated on agar petri dishes. The bacteria would take a week to grow. In order to make the dilutions, four tubes of 10ml sterile broth were obtained and labeled 2,4,6,8. Then, four nutrient agar plates and four nutrient agar plates with tetracycline were collected. Each plate from the two groups were labeled 10-3, 10-5, 10-7, 10-9 with the tetracycline plates also labeled with the word “tet”. The Hay Infusion Culture was then swirled in order to maximize the chances of obtaining different types of bacteria. Then, 100 uL were then taken from the culture and aseptically added to the tube labeled 2 for a 10-2 dilution. Tube 2 was agitated and then again 100uL was taken from tube 2 and added to tube 4 for a 10-4 dilution. This procedure was repeated two more times to make the 10-6 and 10-8 dilutions. Then a 100 uL from the 10-2 tube was taken and placed on the surface of the agar plate labeled 10-3. The same process was used on the “tet” agar plate labeled 10-3. This process was repeated for the rest of the tubes with corresponding agar plates. The agar plates were then placed in an incubator that was set at room temperature for the week.
Conclusion The lab expressed the diversity of life that can exist and grow in a week. When observing the hay infusions it was apparent that many ecosystems can exist even in a jar. For example we found two different species of organisms living in the top part of the water and the bottom part of the water. I look forward to continuing transect experiment and continuing to see the diversity of complex organisms that live in the transect.
--AK
Introduction Bio 2010 01/31/2014
The objectives of this lab were to understand natural selection and understand the biotic and abiotic characteristics of a niche. In order to understand natural selection in this lab we observed characteristics of three different algae families; Volvox, Chlamydomonas, and Gonium. By observing these algae will give us a better understanding of how a simple cellular organism evolved due to natural selection and are able to survive today. These organisms will give us context into natural selection occurring on bigger organisms as we move on in lab.
Similarly, in order to understand biotic and abiotic characteristics of a niche, we observed a transect. By observing a transect will provide insight into how the biosphere works by focussing on biotic and biotic components of a home to many organisms.
Procedure 1: The Volvicine Line In this experiment we observed an isogamous, single celled, motile alga called chlamydomonas. We prepared a slide of a living Chlamydomonas and observed it under a microscope, noting the shape, stigma, nucleus, chloroplast, and flagella. Then we observed a living culture of a Volvox and Gonium on a slide and annotated our observations.
Table 1 Evolutionary Specialization of Members of the Volvocine Line From samples of the three algae a number of characteristics were observed: Number of cells, colony size, functional specialization, and reproductive specialization. The results are contained in the table below.
Characteristic: Number of Cells, Colony Size, Special Function, Reproduction Specialization Bold text Chlamydomonas: 2, 6, Motile, Isogamy
Gonium:3, 5, Still, Oogamy
Volvox:1, 1, Still, Oogamy
Conclusion This lab provided insight into natural selection. By comparing each of these cells it was apparent how evolution by natural selection had a profound effect on the development of theses cells. For example the chlamydomonas ability to photosynthesize in order to survive, give it the ability to live wherever sun and water are available. In order to further this experiment it would be interesting to view one of these single celled organisms next to a cell of a complex organism side by side, and note the differences. This would provide a good contrast on how evolution effects more developed organisms compared to simple ones.
Procedure II: Defining a Niche at AU The lab was split up into five groups of two. Each group was assigned a different transect on the American University Campus. The groups then proceeded to their transect with a 20 foot long string, notebook, and a 50mL sterile conical tube to collect a soil/surface plant sample. Once at the transect the groups were asked to describe general characteristics of the transect, draw a map of the transect, list abiotic and biotic components of the transect, and obtain soil and vegetation sample from the transect using the 50mL sterile tube.
Characteristics of the transect: The transect is located at the Washington Seminary at American University. The transect is a circular plot of plant growth with trees growing out from it. Under the plant growth was rich damp soil which would be perfect conditions to support life, however a weed type growth of plants suffocate the area. Within the growth there were fallen leaves from the trees, sticks, and roots entangling the plants. A tennis ball lay on the outskirts of the circular plot, and a ball of aluminum foil was found in the center of the plot. Surrounding the transect is a grassy hill, the road, and stone park benches.
A list of the abiotic and biotic life we see is listed in a table below:
List of Abiotic and Biotic life:
Abiotic: Soil, Tennis Ball, Aluminum Foil, Park Benches
Biotic: Weed type growth, Trees, Roots, Grass
Conclusion This lab provided insight into the different micro-environments that can occur on any plot of land within a 100 yard radius. At the transect we viewed a whole ecosystem occurring on a 20 ft by 20 ft plot of land. This included seeing a variety of plants and animals that lived in that small plot of land. Using this information as a starting point, it will be interesting over the course of the semester to continue observing the transect and see the different organisms that are currently inhabiting that niche.
-AK